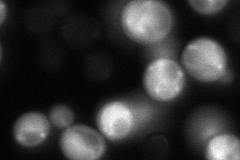

View description
H subunit of the mitochondrial glycine decarboxylase complex, required for the catabolism of glycine to 5,10-methylene-THF; also required for all protein lipoylation; expression is regulated by levels of 5,10-methylene-THF
Localization:
Intensity:
Fold change:
Significance:
-
C’ GFP library in SD

mitochondria128.43 -
N' NOP1pr-GFP in SD

mitochondria228.592 -
N' TEF2pr-mCherry in SD

mitochondria423.311 -
N' NATIVEpr-GFP in SD
cytosol,mitochondria127.685 -
N' TEF2pr-VC and Cyto-VN in SD

#N/A0 -
C’ GFP library in SD+DTT

mitochondria150.441.17No -
C’ GFP library in SD+H2O2

mitochondria167.321.3No -
C’ GFP library in Starvation Media

mitochondria469.53.65Yes -
C’ GFP library on the background of Pup2-DaMP

mitochondria -
C’ GFP library on the background of CCT mutant

mitochondria202.2281.57444Yes
